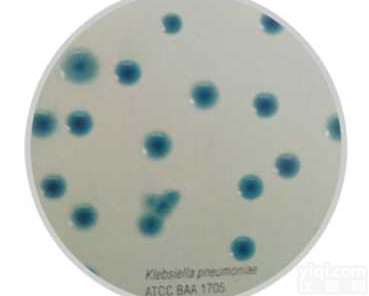
<em>KPC</em>阳性菌<em>显色</em><em>培养基</em>

KPC显色培养基(科玛嘉)
- 品牌:南京便诊
- 型号:BTYW2311H
- 产地:南京
- 供应商:南京乐诊生物技术有限公司
- 供应商报价:¥1120
- 标签:KPC显色培养基(科玛嘉)、KPC显色培养基(科玛嘉)价格、KPC显色培养基(科玛嘉)厂家、、、南京乐诊生物技术有限公司

【产品名称】KPC显色培养基(科玛嘉)
进口显色培养基
| BTYW0012B | 大肠菌群大肠杆菌(ECC)显色培养基(科玛嘉) | 1000ml/瓶 | 用于大肠菌群大肠杆菌分离及鉴定 | |
| BTYW0012F | 沙门氏+菌显色培养基(科玛嘉) | 1000ml/瓶 | 用于沙门氏菌分离及鉴定 | |
| BTYW10128 | 李斯特氏菌鉴定显色培养基(科玛嘉) | 250ml/瓶 | 用于李斯特氏菌分离及鉴定 | |
| BTYW2311F | B族链球菌显色培养基(科玛嘉) | 1000ml/瓶 | 用于B族链球分离及鉴定 | |
| BTYW2311G | ESBL显色培养基(科玛嘉) | 1000ml/瓶 | 用于产超广谱内酰胺酶的耐药菌株分离及鉴定 | |
| BTYW2311H | KPC显色培养基(科玛嘉) | 1000ml/瓶 | 用于对碳青霉烯酶类抗生素敏感度减低的革兰氏阴性菌分离及鉴定 | |
| BTYW2311I | CTX-M显色培养基(科玛嘉) | 1000ml/瓶 | 用于新型超广谱内酰胺酶产生菌CTX-M型的分离及鉴定 | |
| BTYW2311J | 阪崎肠杆菌显色培养基(西班牙conxa) | 1000ml/瓶 | 用于阪崎肠杆菌分离及鉴定 | |
|
|
| |||
【生产公司】
公司名称:南京便诊生物科技有限公司
地 址:南京市江宁区东山街道上元大街808号
联系电话:025-65016260,65016261,52838289,85099525,13951923346,18951960612
传 真:025-52838289
信 箱:njbianzhen@163.com
Q Q: 85026057 2232629373 945313800 QQ群:71118106(检验帝国)
网 址:www.njbianzhen.cn www.njbianzhen.
;